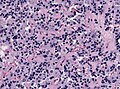

Pituitary gland
The pituitary gland is known as the master gland.
Divisions:[1]
- Anterior pituitary (AKA adenohypophysis, pars distalis).
- Posterior pituitary (AKA neurohypophysis, neural pituitary, pars nervosa).
Function
Anterior
Hormones:[2]
- Growth hormone (GH).
- Luteinizing hormone (LH)
- Follicle-stimulating hormone (FSH)
- Thyroid stimulating hormone (TSH)
- Adrenocorticotropic hormone (ACTH)
- Prolactin (PRL)
Mnemonic: "Go Look For The Adenoma Please" = GH, LH, FSH, TSH, ACTH, PRL.
Intermedia
- Originates from the posterior wall of the Rathke’s pouch.
- Hormones: MSH, ACTH precursor.
- Contains colloid cysts.
Posterior
Hormones:[2]
- Oxytocin.
- Antidiuretic hormone (ADH).
Anatomy and histology
Anatomy
Basic anatomy (simplified):[3]
- Anterior:
- Pars distalis.
- Pars intermedia.
- Posterior:
- Pars nervosa.
Embryological origin:[3]
- Anterior - Rathke's pouch (roof of mouth).
- Posterior - diencephalon (ventral aspect).
Images:
Histology
Anterior
- Acidophils (40% of cells) = red or orange.
- GH, PRL.
- Basophils (10% of cells) = basophilic (light blue).
- TSH, LH, FSH, ACTH.
- Chromophobes (50% of cells) = amphophilic (purplish/grey).
Notes:
- The cellular product (i.e. hormone produced) is not strictly correlated with the cell type.[4]
- The cells can be typed using IHC; somatotrophs (GH), lactotrophs (PRL), corticotrophs (ACTH), thyrotrophs (TSH), gonadotrophs (FSH, LH).[5]
Posterior
Features:[4]
- Herring bodies - key feature.
- Eosinophilic axonal dilations filled with lysosomes and neurosecretory granules.
- Less cellular.
- Usually more cellular in perivascular location.
Image: Herring bodies (ouhsc.edu).
- Pituitary gland histology 2014.jpg
Pituitary gland, low magnification (WC/Athikhun.suw)
DDx for sella turcica lesions
Pituitary necrosis
- Rare.
Causes of pituitary necrosis
- Sheehan syndrome - secondary to blood loss in childbirth.[6]
- Syphilis (fetal-maternal transmission).[7]
- Mollaret's meningitis - very rare.[8] (???)
- Spontaneous necrosis of pituitary tumours - case reports.[9]
Images:
Specific entities
Pituitary neuroendocrine tumor (PitNET)
Old terminology Pituitary adenoma is depreceated. The WHO 2022 Classification of tumours of endocrine organs recoginizes following tumours:[10]
| PitNET lineage | PitNET type | subtypes | Hormone IHC | Transcription factor IHC |
|---|---|---|---|---|
| PIT1 | Somatotroph tumor | Densely and sparsely granulated tumor | GH, a-subunit+/-, CK+ | PIT1 |
| PIT1 | Lactotroph tumor | Densely and sparsely granulated tumor | PRL, CK-ve or weak | PIT1, ER |
| PIT1 | Mammosomatotroph tumor | GH, PRL (usu. less), CK perinuclear +ve | PIT1, ER | |
| PIT1 | Thyrotroph tumor | TSH, CK-ve or weak | PIT1, GATA3 | |
| PIT1 | Mature plurihormonal PIT1 lineage tumor | GH, PRL, TSH, a-subunit +/-ve, CK perinuclear | PIT1, ER, GATA3 | |
| PIT1 | Immature PIT1 lineage tumor | Only focal GH, PRL, TSH, a-subunit +/-ve, CK variable | PIT1, ER +/-ve, GATA3 +/-ve | |
| PIT1 | Acidophilic stem cell tumor | PRL, GH (focal/variable), CK fibrous bodies | PIT1, ER | |
| PIT1 | Mixed somatotroph and lactotroph tumor | PRL, GH (in separate cells) | PIT1, ER (only in lactotroph component) | |
| TPIT | Corticotroph tumor | Densely and sparsely granulated tumors, Crooke cell adenoma | ACTH,CK+ve | TPIT |
| SF1 | Gonadotroph tumor | FSH, LH, a-Subunit or none | SF1, ER, GATA3, CK+/-ve | |
| None | Plurihormonal tumor | All combinations possible | All combinations possible, CK+/-ve | |
| None | Null cell adenoma | None (adenohypophyseal?) | None |
Other tumours may be classified as plurhormonal or double adenomas or as adenomas with unusual IHC combination.
General
- Clinical:[11]
- Classically: visual field defects (bitemporal hemianopsia).
- Others (increased intracranial pressure): headache, nausea, vomiting.
- Tumor of adults.
Morphologic Classification:
- Microtumor <= 1 cm.
- Macrotumor 1-4 cm.
- Giant tumor > 4cm.
May be classified by what they secrete.
- Functional (endocrine hyperfunction).
- Acromegaly/giantism.
- Hyperprolactinemia.
- Cushing disease.
- Hyperthyroidism.
- Significant elevation of FSH/LH.
- Clinically nonfunctioning.
Notes:
Cushing disease is due to pituitary gland hypersecretion of ACTH (due to a pituitary adenoma or CRH hypersecretion from the hypothalamus).[12] Cushing syndrome is hypercortisolism not due to pituitary gland pathology.
Imaging:
- Sellar enlargement.
- Bone erosion, invasive growth esp. cavernous sinus (35-45%).
- Inhomogenous signal in T1w MRI.
Familial pituitary adenomas
A pituitary adenoma may be part of a familial syndrome:[13][14]
| Syndrome | Gene | Notes |
|---|---|---|
| Multiple endocrine neoplasia I | MEN1 | characterized by the 3 Ps: pituitary adenoma, parathyroid adenoma, pancreatic neuroendocrine tumour |
| MEN-1-like syndrome | CDKN1B[15] | also known as Multiple endocrine neoplasia IV [15] |
| Carney syndrome | PRKAR1A | other findings (mnemonic NAME): nevi, atrial myxoma, myxoid neurofibroma, ephelides (freckles) |
| Isolated pituitary adenoma[16] | AIP | classically GH-producing adenoma - leads to acromegaly |
Microscopic
Features:[17]
- Loss of fibrous stroma.
- The cells of a normal (anterior) pituitary are nested.
- Basophilic cells (corticotrophs).
- Eosinophilic cells(somatotrophs).
- Extensive fibrosis often seen in TSH-producing tumors.
Notes:
- Smears very well.[18]
Images
- Nonfunctioning pituitary adenoma (1).jpg
Pituitary adenoma - non-functioning. (WC/KGH)
- HE fibrosis pituitary adenoma.jpg
Extensive interstitial and perivascular fibrosis in a pituitary adenoma (WC/jensflorian)
Pituitary adenoma - PRL producing, HE. Note the basophilic appearance of the cells (WC/jensflorian)
- Densely granulated HGH producing adenoma.jpg
Pituitary adenoma - HGH producing, HE. The cells have a slightly eosinophilic appearance (WC/jensflorian)
- Sparsely granulated HGH adenoma.jpg
Sparsely granulated adenoma - HGH producing. Note the numerous fibrous bodies in HE stain (WC/jensflorian)
Pituitary adenoma - TSH producing. TSH IHC can be heterogeneous (WC/jensflorian)
- Pituitary adenoma (1) GH production.jpg
Pituitary adenoma - GH producing. (WC/KGH)
- HE-GHoma.jpg
Pituitary adenoma , HE. This gonadotropin producing adenoma has a papillary architecture (WC/jensflorian)
Pituitary adenoma, IHC for FSH (WC/jensflorian)
Pituitary adenoma, IHC for LH (WC/jensflorian)
- ACTHoma-IHC.jpg
Pituitary adenoma , ACTH producing. Strong ACTH IHC in this basophilic adenoma (WC/jensflorian)
- Pituitary adenoma-nonfunctioning.jpg
Pituitary adenoma with vascular pseudorosettes, nonfunctioning (WC/jensflorian)
- Crooke Cytokeratins.jpg
Crooke cell adenoma, panCK (WC/Marvin101)
- HE fibrosis pituitary adenoma.jpg
Fibrosis in pituitary adenoma.
Stains
- Reticulin - loss of reticulin between tumour cells.
IHC
- LH.
- FSH.
- TSH - Hyperthyroidism
- GH - Acromegaly.
- Prolactin -Galactorrhea, Amenorrhea, Gynecomastia. Golgi staining pattern in sparsely granulated cases.
- ACTH - Cushing syndrome.
- PIT-1: stains somatotrophs, lactotrophs and thyrothrops.
- TPIT: stains corticotrophs.
- SF1: stains gonadotrophs.
- Chromogranin A +ve
- Synaptophysin strongly +ve (except lactotrophs)
- CAM5.2: fibrous bodies in sparsely granulated somatotroph adenoma, Ring-like staining in Crooke cell adenoma.
- MIB-1: Usu less than 3%.
Note: Null-cell adenoma must be hormone immunonegative and negative for transcription factors.
Variants
- Corticotroph adenomas exhibiting Crooke's hyaline change: agressive course.[19]
- Acidophilic stem cell adenomas: large, locally invasive adenoma with low GH activity. [20]
- Sparsely granulated somatotroph adenomas are more invasive than other variants and respond less to medical treatment. [21]
- Lactotroph adenomas in men may show aggressive clinical behavior. [22]
- Immature PIT-1 lineage tumors may show aggresive growth. [23]
Molecular
- GNAS mutations frequently in densely granulated somatotroph tumors.
Pituitary blastoma
- New entity introduced in 2017[24]
- Epithelial glands with rosette-like formations resembling immature Rathke epithelium.
- Synaptophysin +ve, usu. ACTH+ve
- DICER1 mutations[25]
Pituitary carcinoma
- Depreceated in the WHO2022 classification.
- It is acknowledged that PitNETs can be invasive or spread to other sites.
Rathke cleft cyst
General
- Benign counterpart of craniopharyngioma.
- Arises from intermediate lobe of pituitary gland (pars intermedia of pituitary gland).
Radiology:
- Typically no calcifications.[26]
Radiologic DDx:[26]
- Arachnoid cyst.
- Craniopharyngioma.
- Cysticercosis.
- Pituitary adenoma.
- Epidermoid of brain.
Microscopic
Features:
- Lined by a layer of cuboidal or columnar epithelial with cilia.
- +/-Goblet cells.[27]
- +/-Squamous metaplasia ~ may be several layers thick.
- May be confused with papillary craniopharyngioma.[28]
- Cholesterol clefts may be seen in association with rupture.[29]
DDx:
Images:
Craniopharyngioma
Gangliocytoma
- Neuronal cells in abundant neuropil.
- S-100, Synaptophysin +ve.
- Isolated sellar cases are very rare.
Image: [[1]]
Mixed Gangliocytoma-adenoma
AKA: ganglioneuroma, pituitary adenoma with neuronal choristoma (PANCH)
- Neuronal cells mixed with pituitary adenoma cells.
- Approx. 0.25% of all pituitary adenomas.
- Association with somatotroph adenomas (acromegaly).
Pituicytoma
Spindle cell oncocytoma
- Origin: Neurohypophysis or infundibulum.
- Benign clinical course - WHO grade I.
- Elongated bipolar, spindle cells.
- Fascicular or storiform growth patterns.
- EMA: patchy, S-100+/-ve, GFAP+/-ve, TTF1+ve.
- It is thought that Spindle cell oncocytomas and Granular cell tumors of the neurohypophysis are variants of Pituicyoma.[30]
Granular cell tumor of the sellar region
- Origin: Neurohypophysis or infundibulum.
- Benign clinical course - WHO grade I.
- Well circumscribed.
- Polygonal cells with abundant granular cytoplasm.
- CD68+ve, S-100+/-ve, GFAP+/-ve, TTF1+ve.
Autoimmune hypophysitis
General
Features:[31]
- Rare.
- Autoantigens are unknown.
- May occur in pregnancy.
- May be misdiagnosed as a nonsecreting adenoma.
Microscopic
Features:[31]
- Lymphocytic infiltration.
Lymphocytic hypophysitis, CD3 IHC. (WC/jensflorian)
See also
References
- ↑ http://www.vivo.colostate.edu/hbooks/pathphys/endocrine/hypopit/histo.html
- ↑ 2.0 2.1 http://users.rcn.com/jkimball.ma.ultranet/BiologyPages/P/Pituitary.html
- ↑ 3.0 3.1 URL: http://www.vivo.colostate.edu/hbooks/pathphys/endocrine/hypopit/histo_pit.html. Accessed on: 31 October 2010.
- ↑ 4.0 4.1 Perry, Arie; Brat, Daniel J. (2010). Practical Surgical Neuropathology: A Diagnostic Approach: A Volume in the Pattern Recognition series (1st ed.). Churchill Livingstone. pp. 26. ISBN 978-0443069826.
- ↑ Kumar, Vinay; Abbas, Abul K.; Fausto, Nelson; Aster, Jon (2009). Robbins and Cotran pathologic basis of disease (8th ed.). Elsevier Saunders. pp. 1098-9. ISBN 978-1416031215.
- ↑ URL: http://www.mayoclinic.com/health/sheehans-syndrome/DS00889. Accessed on: 16 November 2010.
- ↑ URL: http://pediatrics.aappublications.org/cgi/content/full/104/1/e4. Accessed on: 16 November 2010.
- ↑ Dancer CM, Woods ML, Henderson RD, Robertson T, Mungomery M, Allworth A (July 2008). "Mollaret's meningitis and pituitary failure associated with a Rathke's cleft cyst". Intern Med J 38 (7): 609–11. doi:10.1111/j.1445-5994.2008.01709.x. PMID 18715308.
- ↑ Sachdev Y, Evered DC, Hall R (April 1976). "Spontaneous pituitary necrosis". Br Med J 1 (6015): 942. PMC 1639254. PMID 1268492. http://www.ncbi.nlm.nih.gov/pmc/articles/PMC1639254/pdf/brmedj00512-0028a.pdf.
- ↑ "Overview of the 2022 WHO Classification of Pituitary Tumors". Endocr Pathol 33 (1): 6–26. March 2022. doi:10.1007/s12022-022-09703-7. PMID 35291028.
- ↑ Kumar, Vinay; Abbas, Abul K.; Fausto, Nelson; Aster, Jon (2009). Robbins and Cotran pathologic basis of disease (8th ed.). Elsevier Saunders. pp. 1100. ISBN 978-1416031215.
- ↑ Kumar, Vinay; Abbas, Abul K.; Fausto, Nelson; Aster, Jon (2009). Robbins and Cotran pathologic basis of disease (8th ed.). Elsevier Saunders. pp. 1148. ISBN 978-1416031215.
- ↑ Elston, MS.; McDonald, KL.; Clifton-Bligh, RJ.; Robinson, BG. (Aug 2009). "Familial pituitary tumor syndromes.". Nat Rev Endocrinol 5 (8): 453-61. doi:10.1038/nrendo.2009.126. PMID 19564887.
- ↑ Mitchell, Richard; Kumar, Vinay; Fausto, Nelson; Abbas, Abul K.; Aster, Jon (2011). Pocket Companion to Robbins & Cotran Pathologic Basis of Disease (8th ed.). Elsevier Saunders. pp. 554. ISBN 978-1416054542.
- ↑ 15.0 15.1 Online 'Mendelian Inheritance in Man' (OMIM) 600778
- ↑ Korbonits, M.; Storr, H.; Kumar, AV. (May 2012). "Familial pituitary adenomas - Who should be tested for AIP mutations?". Clin Endocrinol (Oxf). doi:10.1111/j.1365-2265.2012.04445.x. PMID 22612670.
- ↑ Perry, Arie; Brat, Daniel J. (2010). Practical Surgical Neuropathology: A Diagnostic Approach: A Volume in the Pattern Recognition series (1st ed.). Churchill Livingstone. pp. 36. ISBN 978-0443069826.
- ↑ MUN. 24 November 2010.
- ↑ George, DH.; Scheithauer, BW.; Kovacs, K.; Horvath, E.; Young, WF.; Lloyd, RV.; Meyer, FB. (Oct 2003). "Crooke's cell adenoma of the pituitary: an aggressive variant of corticotroph adenoma.". Am J Surg Pathol 27 (10): 1330-6. PMID 14508394.
- ↑ Horvath, E.; Kovacs, K.; Singer, W.; Smyth, HS.; Killinger, DW.; Erzin, C.; Weiss, MH. (Feb 1981). "Acidophil stem cell adenoma of the human pituitary: clinicopathologic analysis of 15 cases.". Cancer 47 (4): 761-71. PMID 6261917.
- ↑ Kato, M.; Inoshita, N.; Sugiyama, T.; Tani, Y.; Shichiri, M.; Sano, T.; Yamada, S.; Hirata, Y. (2012). "Differential expression of genes related to drug responsiveness between sparsely and densely granulated somatotroph adenomas.". Endocr J 59 (3): 221-8. PMID 22200580.
- ↑ Delgrange, E.; Vasiljevic, A.; Wierinckx, A.; François, P.; Jouanneau, E.; Raverot, G.; Trouillas, J. (Jun 2015). "Expression of estrogen receptor alpha is associated with prolactin pituitary tumor prognosis and supports the sex-related difference in tumor growth.". Eur J Endocrinol 172 (6): 791-801. doi:10.1530/EJE-14-0990. PMID 25792376.
- ↑ Mete, O.; Gomez-Hernandez, K.; Kucharczyk, W.; Ridout, R.; Zadeh, G.; Gentili, F.; Ezzat, S.; Asa, SL. (Feb 2016). "Silent subtype 3 pituitary adenomas are not always silent and represent poorly differentiated monomorphous plurihormonal Pit-1 lineage adenomas.". Mod Pathol 29 (2): 131-42. doi:10.1038/modpathol.2015.151. PMID 26743473.
- ↑ Lopes, MBS. (Oct 2017). "The 2017 World Health Organization classification of tumors of the pituitary gland: a summary.". Acta Neuropathol 134 (4): 521-535. doi:10.1007/s00401-017-1769-8. PMID 28821944.
- ↑ de Kock, L.; Sabbaghian, N.; Plourde, F.; Srivastava, A.; Weber, E.; Bouron-Dal Soglio, D.; Hamel, N.; Choi, JH. et al. (Jul 2014). "Pituitary blastoma: a pathognomonic feature of germ-line DICER1 mutations.". Acta Neuropathol 128 (1): 111-22. doi:10.1007/s00401-014-1285-z. PMID 24839956.
- ↑ 26.0 26.1 URL: http://emedicine.medscape.com/article/343629-overview. Accessed on: 14 November 2010.
- ↑ URL: http://www.endotext.org/neuroendo/neuroendo3/neuroendo3.html. Accessed on: 27 May 2010.
- ↑ Perry, Arie; Brat, Daniel J. (2010). Practical Surgical Neuropathology: A Diagnostic Approach: A Volume in the Pattern Recognition series (1st ed.). Churchill Livingstone. pp. 408. ISBN 978-0443069826.
- ↑ URL: http://path.upmc.edu/cases/case177/dx.html. Accessed on: 8 January 2012.
- ↑ Mete, O.; Lopes, MB.; Asa, SL. (Nov 2013). "Spindle cell oncocytomas and granular cell tumors of the pituitary are variants of pituicytoma.". Am J Surg Pathol 37 (11): 1694-9. doi:10.1097/PAS.0b013e31829723e7. PMID 23887161.
- ↑ 31.0 31.1 Tzou SC, Lupi I, Landek M, et al. (July 2008). "Autoimmune hypophysitis of SJL mice: clinical insights from a new animal model". Endocrinology 149 (7): 3461–9. doi:10.1210/en.2007-1692. PMC 2453094. PMID 18388197. https://www.ncbi.nlm.nih.gov/pmc/articles/PMC2453094/.
External links
- Neuropathology - neuropathologyweb.org.
- Endocrine histology (anhb.uwa.edu.au).